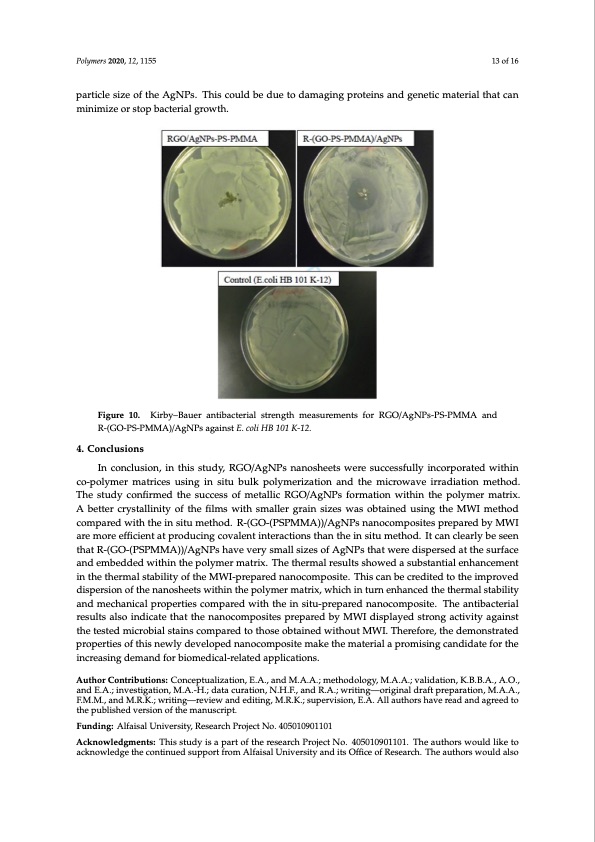

PDF Publication Title:
Text from PDF Page: 013
Polymers 2020, 12, 1155 13 of 16 particle size of the AgNPs. This could be due to damaging proteins and genetic material that can mPoliynmimersiz20e2o0,r1s2,toxpFObRacPtEeErRiaRlEgVrIoEwWth. 13 of 16 Figure1100..KirKbiyr–bBya–uBearuaenrtiabnatcitbearciatelrsitarlensgtrthenmgtehasmureamsuenretsmfeonrtRsGfOor/ARgGNOP/sA-PgSN-PMs-MPSA-PaMndMRA-(GanOd- RPS-(-GPMO-MPSA-P)/MAgMNAP)s/AagNainPstaEg.acionlsitHEB. c1o0li1HKB-1120.1 K-12. 4. Conclusions 4. Conclusions In conclusion, in this study, RGO/AgNPs nanosheets were successfully incorporated within In conclusion, in this study, RGO/AgNPs nanosheets were successfully incorporated within co- co-polymer matrices using in situ bulk polymerization and the microwave irradiation method. polymer matrices using in situ bulk polymerization and the microwave irradiation method. The The study confirmed the success of metallic RGO/AgNPs formation within the polymer matrix. study confirmed the success of metallic RGO/AgNPs formation within the polymer matrix. A better A better crystallinity of the films with smaller grain sizes was obtained using the MWI method crystallinity of the films with smaller grain sizes was obtained using the MWI method compared with compared with the in situ method. R-(GO-(PSPMMA))/AgNPs nanocomposites prepared by MWI the in situ method. R-(GO-(PSPMMA))/AgNPs nanocomposites prepared by MWI are more efficient are more efficient at producing covalent interactions than the in situ method. It can clearly be seen at producing covalent interactions than the in situ method. It can clearly be seen that R-(GO- that R-(GO-(PSPMMA))/AgNPs have very small sizes of AgNPs that were dispersed at the surface (PSPMMA))/AgNPs have very small sizes of AgNPs that were dispersed at the surface and and embedded within the polymer matrix. The thermal results showed a substantial enhancement embedded within the polymer matrix. The thermal results showed a substantial enhancement in the in the thermal stability of the MWI-prepared nanocomposite. This can be credited to the improved thermal stability of the MWI-prepared nanocomposite. This can be credited to the improved dispersion of the nanosheets within the polymer matrix, which in turn enhanced the thermal stability dispersion of the nanosheets within the polymer matrix, which in turn enhanced the thermal stability and mechanical properties compared with the in situ-prepared nanocomposite. The antibacterial and mechanical properties compared with the in situ-prepared nanocomposite. The antibacterial results also indicate that the nanocomposites prepared by MWI displayed strong activity against results also indicate that the nanocomposites prepared by MWI displayed strong activity against the the tested microbial stains compared to those obtained without MWI. Therefore, the demonstrated tested microbial stains compared to those obtained without MWI. Therefore, the demonstrated properties of this newly developed nanocomposite make the material a promising candidate for the properties of this newly developed nanocomposite make the material a promising candidate for the increasing demand for biomedical-related applications. increasing demand for biomedical-related applications. Author Contributions: Conceptualization, E.A., and M.A.A.; methodology, M.A.A.; validation, K.B.B.A., A.O., Author Contributions: Conceptualization, E.A., and M.A.; methodology, M.A.; validation, K.A, A.O., and E.A.; and E.A.; investigation, M.A.-H.; data curation, N.H.F., and R.A.; writing—original draft preparation, M.A.A., investigation, M.A.-H.; data curation, N.F., and R.A.; writing—original draft preparation, M.A., F.M., and M.K.; F.M.M., and M.R.K.; writing—review and editing, M.R.K.; supervision, E.A. All authors have read and agreed to twhreitpinugb—lisrheevdievwerasniodneodfitihnegm, Man.Ku.s;csruipte.rvision, E.A.; all authors have read and agreed to the published version of the manuscript. Funding: Alfaisal University, Research Project No. 405010901101 Funding: Alfaisal University, Research Project No. 405010901101 Acknowledgments: This study is a part of the research Project No. 405010901101. The authors would like to acknowledge the continued support from Alfaisal University and its Office of Research. The authors would also Acknowledgments: This study is a part of the research Project No. 405010901101. The authors would like to acknowledge the continued support from Alfaisal University and its Office of Research. The authors would also like to express their sincere gratitude to King Abdul-Aziz City for Science and Technology (KACST), Riyadh, Saudi Arabia, for their valuable and continuous scientific and moral support. Conflicts of Interest: The authors declare no conflicts of interest.PDF Image | Microwave Irradiation Synthesis Silver Nanoparticle
PDF Search Title:
Microwave Irradiation Synthesis Silver NanoparticleOriginal File Name Searched:
polymers-12-01155-v2.pdfDIY PDF Search: Google It | Yahoo | Bing
Turbine and System Plans CAD CAM: Special for this month, any plans are $10,000 for complete Cad/Cam blueprints. License is for one build. Try before you buy a production license. More Info
Waste Heat Power Technology: Organic Rankine Cycle uses waste heat to make electricity, shaft horsepower and cooling. More Info
All Turbine and System Products: Infinity Turbine ORD systems, turbine generator sets, build plans and more to use your waste heat from 30C to 100C. More Info
CO2 Phase Change Demonstrator: CO2 goes supercritical at 30 C. This is a experimental platform which you can use to demonstrate phase change with low heat. Includes integration area for small CO2 turbine, static generator, and more. This can also be used for a GTL Gas to Liquids experimental platform. More Info
Introducing the Infinity Turbine Products Infinity Turbine develops and builds systems for making power from waste heat. It also is working on innovative strategies for storing, making, and deploying energy. More Info
Need Strategy? Use our Consulting and analyst services Infinity Turbine LLC is pleased to announce its consulting and analyst services. We have worked in the renewable energy industry as a researcher, developing sales and markets, along with may inventions and innovations. More Info
Made in USA with Global Energy Millennial Web Engine These pages were made with the Global Energy Web PDF Engine using Filemaker (Claris) software.
Infinity Turbine Developing Spinning Disc Reactor SDR or Spinning Disc Reactors reduce processing time for liquid production of Silver Nanoparticles.
| CONTACT TEL: 608-238-6001 Email: greg@infinityturbine.com | RSS | AMP |